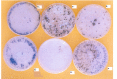

Isolation and fusion of protoplasts from the phytopathogenic fungus sclerotium rolfsii(sacc.)
- PMID: 24031488
- PMCID: PMC3768609
- DOI: 10.1590/S1517-838220100001000035
Isolation and fusion of protoplasts from the phytopathogenic fungus sclerotium rolfsii(sacc.)
Abstract
Sclerotium rolfsii (Sacc.) is a serious plant pathogenic fungus and lacks perfect (basidial) stage in production. Protoplast fusion technology was employed to reconstruct fusants from this fungus. Two strains designated as A and R were used. Maximum protoplast yields of 3.8x10(5)/g mycelia and 2.8x10(5)/g mycelia were formed in strains A and R respectively. Osmotic stabilizer sucrose 1M gave maximum yield. Lysing enzyme at the rate of 15mg/ml was found best for yield. Fusion of protoplasts from strains A and R was carried out in fusion media containing PEG 4000 30% (w/v) with 0.2mM CaCl2. Four fusants F1, F2, F3 and F4 were recovered. Morphological, physiological and pathogenic characters of fusants were compared with parent strains on carrots, beans and tomato.
Keywords: Pathogenicity; Protoplast; Sclerotium rolfsii; fusion; osmotic stabilizer.
Figures

Similar articles
-
Influence of protoplast fusion between two Trichoderma spp. on extracellular enzymes production and antagonistic activity.Biotechnol Biotechnol Equip. 2014 Nov 2;28(6):1014-1023. doi: 10.1080/13102818.2014.978206. Epub 2014 Nov 14. Biotechnol Biotechnol Equip. 2014. PMID: 26019588 Free PMC article.
-
Interspecific hybridization between Ganoderma lingzhi and G. applanatum through protoplast fusion.World J Microbiol Biotechnol. 2021 Jun 11;37(7):114. doi: 10.1007/s11274-021-03084-5. World J Microbiol Biotechnol. 2021. PMID: 34115218
-
Molecular heterozygosity and genetic exploitations of Trichoderma inter-fusants enhancing tolerance to fungicides and mycoparasitism against Sclerotium rolfsii Sacc.Infect Genet Evol. 2018 Dec;66:26-36. doi: 10.1016/j.meegid.2018.09.005. Epub 2018 Sep 13. Infect Genet Evol. 2018. PMID: 30219319
-
Formation and regeneration of protoplasts in Sclerotium rolfsii ATCC 201126.J Appl Microbiol. 2004;96(2):254-62. doi: 10.1046/j.1365-2672.2003.02145.x. J Appl Microbiol. 2004. PMID: 14723686
-
Regeneration and molecular characterization of an intergeneric hybrid between Graphium putredinis and Trichoderma harzianum by protoplasmic fusion.Biotechnol Adv. 2010 May-Jun;28(3):285-92. doi: 10.1016/j.biotechadv.2009.12.007. Epub 2010 Jan 11. Biotechnol Adv. 2010. PMID: 20064604 Review.
Cited by
-
Influence of protoplast fusion between two Trichoderma spp. on extracellular enzymes production and antagonistic activity.Biotechnol Biotechnol Equip. 2014 Nov 2;28(6):1014-1023. doi: 10.1080/13102818.2014.978206. Epub 2014 Nov 14. Biotechnol Biotechnol Equip. 2014. PMID: 26019588 Free PMC article.
-
Optimization of Polyethylene Glycol-Mediated Transformation of the Pepper Anthracnose Pathogen Colletotrichum scovillei to Develop an Applied Genomics Approach.Plant Pathol J. 2019 Dec;35(6):575-584. doi: 10.5423/PPJ.OA.06.2019.0171. Epub 2019 Dec 12. Plant Pathol J. 2019. PMID: 31832038 Free PMC article.
-
Microbial Lipid Based Biorefinery Concepts: A Review of Status and Prospects.Foods. 2023 May 22;12(10):2074. doi: 10.3390/foods12102074. Foods. 2023. PMID: 37238892 Free PMC article. Review.
References
-
- Anne J. Comparison of penicillins produced by inter-species hybrids from Pencillium chrysogenum. European Journal of Microbial Biotechnology. 1982;15:41–46.
-
- Anne J., Peberdy J.F. Conditions for induced fusion of fungal protoplasts in polyethylene glycol solutions. Arch. Microbiol. 1975;105:201–205. - PubMed
-
- Butler W.L., Kitajima M. A tripartiate model for chloroplast fluorescence. In: Avron M., editor. Proceeding of the 3rd International Congress on Photosynthesis. Amsterdam: Elsevier; 1975. pp. 13–24.
-
- Cheng Y., Belanger R.R. Protoplast preparation and regeneration from the spores of the bio-control fungus Pseudozyma flocculosa. FEMS Microbiol. Lett. 2000;190:287–291. - PubMed
-
- Christias C. Specific inhibition of sclerotium formation by 2-mercaptoethanol and related sulfhydryl compounds in Sclerotium rolfsii. Can. J. Microbiol. 1975;21:1541–1547. - PubMed
LinkOut - more resources
Full Text Sources
Other Literature Sources
Miscellaneous